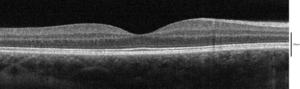

التصوير المقطعي للترابط البصري
| التصوير المقطعي للترابط لابصري | |
|---|---|
 صورة بالتصوير المقطعي للترابط البصري للغرن | |
| MeSH | D041623 |
| OPS-301 code | 3-300 |
التصوير المقطعي للترابط البصري (إنگليزية: Optical coherence tomography، اختصاراً OCT)هو تقنية تصوير تستخدم ضوءًا منخفض الترابط لالتقاط صور بدقة الميكرومتر وثنائية وثلاثية الأبعاد من داخل وسائط التشتت البصري (على سبيل المثال ، الأنسجة البيولوجية). يتم استخدامه للتصوير الطبي والاختبار الصناعي الغير تدميري (NDT). يعتمد التصوير المقطعي للترابط البصري على قياس التداخل منخفض الترابط ، وعادةً ما يستخدم ضوء الأشعة تحت الحمراء القريبة. يسمح استخدام الضوء ذي الطول الموجي الطويل نسبيًا باختراق وسط التشتت. الفحص المجهري المُبائِر ، وهو تقنية بصرية أخرى ، يخترق العينة بعمق أقل ولكن بدقة أعلى..
اعتمادًا على خصائص مصدر الضوء (تم استخدام الثنائيات فائقة الإضاءة ، والليزر النبضي فائق القصر ، والليزر الفائق السرعة) ، حقق التصوير المقطعي للترابط البصري دقة دون الميكرومتر (مع مصادر واسعة النطاق للغاية تنبعث من أكثر من تقريبا 100 نانومتر في نطاق الطول الموجي). .[بحاجة لمصدر]قالب:Verification needed
التصوير المقطعي للترابط البصري هو أحد فئات تقنيات التصوير المقطعي البصري.[بحاجة لمصدر] تُستخدم أنظمة التصوير المقطعي بالترابط البصري المتاحة تجارياً في تطبيقات متنوعة ، بما في ذلك الحفاظ على الفن والطب التشخيصي ، ولا سيما في طب العيون وتصحيح البصر حيث يمكن استخدامها للحصول على صور مفصلة من داخل شبكية العين.[بحاجة لمصدر] في الآونة الأخيرة ، بدأ أيضًا استخدامه في طب القلب التداخلية للمساعدة في تشخيص مرض الشريان التاجي,[1] وفي طب الجلد لتحسين التشخيص.[2] يوفر تطبيق حديث نسبيًا للتصوير المقطعي للترابط البصري ، التصوير المقطعي الترابطي البصري لمجال التردد ، مزايا في نسبة الإشارة إلى الضجيج المقدمة ، مما يسمح بالحصول على إشارة أسرع.[بحاجة لمصدر]
مقدمة
بدءًا من عمل أدولف فيرشر وزملائه على الترابط المنخفض والجزئي أو قياس التداخل بالضوء الأبيض لقياسات العين في الجسم الحي [3][4] في فيينا في الثمانينيات ، تم فحص تصوير الأنسجة البيولوجية ، وخاصة العين البشرية. بالتوازي مع مجموعات متعددة في جميع أنحاء العالم. تم تقديم أول تصوير ثنائي الأبعاد في الجسم الحي لقاع العين البشرية على طول خط الطول الأفقي بناءً على عمليات مسح عمق الضوء الأبيض المتداخل في مؤتمر ICO-15 SAT في عام 1990.[5] تم تطويره في عام 1990 بواسطة Naohiro Tanno,[6][7] ثم أستاذًا في جامعة ياماجاتا ، تمت الإشارة إليه على أنه التصوير المقطعي الانعكاسي الغير متجانس ، وعلى وجه الخصوص منذ عام 1991 بواسطة هوانج واخرون. ،عند مختبر البروفيسور جيمس فوجيموتو في معهد ماساتشوستس للتكنولوجيا,[8] الذي صاغ مصطلح "التصوير المقطعي للترابط البصري" بنجاح. منذ ذلك الحين ، أصبحت تقنية التصوير المقطعي للترابط البصري (OCT) ذات الدقة الميكرومترية وقدرات التصوير المقطعي تقنية بارزة لتصوير الأنسجة الطبية الحيوية والتي اكتسبت باستمرار إمكانات تقنية جديدة بدءًا من الكشف المبكر عن الإشارات الإلكترونية ، من خلال استخدام أشعة الليزر ذات النطاق العريض ومصفوفات البكسل الخطية لأشعة الليزر فائقة السرعة القابلة للضبط من أجل توسيع مغلف أدائها وحساسيتها.
وهي مناسبة بشكل خاص لتطبيقات العيون وغيرها من صور الأنسجة التي تتطلب دقة ميكرومترية وعمق اختراق ميليمتري[9] تم نشر صور التصوير المقطعي للترابط البصري الأولى في الجسم الحي - التي تعرض بنىات الشبكية - في عام 1993 وأول صور بالمنظار في عام 1997.[10][11] تم استخدام التصوير المقطعي للترابط البصري أيضًا في العديد من مشاريع الحفاظ على الفن ، حيث يتم استخدامه لتحليل الطبقات المختلفة في اللوحة. يتمتع التصوير المقطعي للترابط البصري بمزايا مثيرة للاهتمام مقارنة بأنظمة التصوير الطبي الأخرى. التصوير بالموجات فوق الصوتية الطبية ، والتصوير بالرنين المغناطيسي (MRI) ، والفحص المجهري المُبائِر ، و التصوير المقطعي للترابط البصري مناسب بشكل مختلف لتصوير الأنسجة المورفولوجية: في حين أن الأول والثاني لهما قدرة تصوير بالجسم بالكامل ولكن منخفضة الدقة (عادةً جزء من ملليمتر) ، يمكن للثالث توفير صور بدقة أقل بكثير من 1 ميكرومتر (أي شبه خلوي) ، يتراوح عمقها بين 0 و 100 ميكرومتر ، ويمكن للرابع أن يسبر بعمق يصل إلى 500 ميكرومتر ، ولكن بدقة أقل (أي معمارية) (حوالي 10 ميكرومتر في الجانب وبضعة ميكرومتر في العمق في طب العيون ، على سبيل المثال ، و 20 ميكرومتر في التنظير الجانبي).[12][13]
يعتمد التصوير المقطعي للترابط البصري على قياس التداخل منخفض الترابط.[14][15][صفحة مطلوبة][4] في قياس التداخل التقليدي بطول ترابط طويل (أي قياس التداخل بالليزر) ، يحدث تداخل الضوء على مسافة أمتار. في التصوير المقطعي للترابط البصري ، يتم تقصير هذا التداخل إلى مسافة ميكرومتر ، بسبب استخدام مصادر الضوء ذات النطاق الترددي العريض (أي المصادر التي تنبعث الضوء على نطاق واسع من الترددات). يمكن توليد الضوء ذي النطاقات العريضة باستخدام الثنائيات فائقة الإضاءة أو أشعة الليزر ذات النبضات القصيرة للغاية ( ليزر الفيمتو ثانية ). الضوء الأبيض هو مثال على مصدر واسع النطاق بطاقة أقل.
ينقسم الضوء في نظام التصوير المقطعي للترابط البصري إلى ذراعين - ذراع عينة (تحتوي على العنصر المثير للاهتمام) وذراع مرجعي (عادةً مرآة). يؤدي الجمع بين الضوء المنعكس من ذراع العينة والضوء المرجعي من الذراع المرجعية إلى ظهور نمط تداخل ، ولكن فقط إذا كان الضوء من كلا الذراعين قد قطع المسافة الضوئية "نفسها" (تعني "نفسها" اختلافًا أقل من طول الترابط). عن طريق مسح المرآة في الذراع المرجعية ، يمكن الحصول على ملف انعكاسي للعينة (هذا هو المجال الزمني لالتصوير المقطعي للترابط البصري). ستؤدي مناطق العينة التي تعكس قدرًا كبيرًا من الضوء إلى حدوث تداخل أكبر من المناطق التي لا تعكس ذلك. أي ضوء خارج طول الترابط القصير لن يتداخل.[16] يحتوي ملف الانعكاسية هذا ، المسمى المسح أ ، على معلومات حول الأبعاد المكانية وموقع الهياكل داخل العنصر محل الاهتمام. يمكن تحقيق التصوير المقطعي المستعرض ( مسح-ب ) من خلال الجمع بين سلسلة من عمليات المسح المحوري للعمق (مسح-أ). يمكن تصوير الوجه على العمق المكتسب اعتمادًا على محرك التصوير المستخدم..
تفسير لايپرسون

التصوير المقطعي للتماسك البصري ، (OCT) ، هو تقنية للحصول على صور تحت السطح لمواد شفافة أو معتمة بدقة تعادل مجهر منخفض الطاقة. إنها "الموجات فوق الصوتية الضوئية" بشكل فعال ، وهي انعكاسات تصويرية من داخل الأنسجة لتوفير صور مقطعية..[17]
اجتذب التصوير المقطعي للتماسك البصري اهتمام المجتمع الطبي لأنه يوفر صورًا لمورفولوجيا الأنسجة بدقة أعلى بكثير (أقل من 10 ميكرومتر محوريًا وأقل من 20 ميكرومتر جانبياً[18]من طرق التصوير الأخرى مثل التصوير بالرنين المغناطيسي أو الموجات فوق الصوتية..
الفوائد الرئيسية للتصوير المقطعي للترابط البصري هي:
- صور حية تحت السطح بدقة شبه مجهرية
- التصوير الفوري والمباشر لتشكل الأنسجة
- لا يوجد تحضير للعينة أو الموضوع ، لا يوجد اتصال
- لا إشعاع مؤين
يوفر التصوير المقطعي للترابط البصري دقة عالية لأنه يعتمد على الضوء بدلاً من الصوت أو تردد الراديو. يتم توجيه شعاع ضوئي إلى النسيج ، ويتم جمع جزء صغير من هذا الضوء الذي ينعكس من ميزات تحت السطح. لاحظ أن معظم الضوء لا ينعكس بل يتشتت بزوايا كبيرة. في التصوير التقليدي ، يساهم هذا الضوء المنتشر في الخلفية التي تحجب الصورة. ومع ذلك ، في التصوير المقطعي للترابط البصري ، يتم استخدام تقنية تسمى قياس التداخل لتسجيل طول المسار البصري للفوتونات المستقبلة مما يسمح برفض معظم الفوتونات التي تنتشر عدة مرات قبل الاكتشاف. وبالتالي ، يمكن للتصوير المقطعي للترابط البصري تكوين صور ثلاثية الأبعاد واضحة لعينات سميكة عن طريق رفض إشارة الخلفية أثناء جمع الضوء المنعكس مباشرة من الأسطح محل الاهتمام.
ضمن نطاق تقنيات التصوير ثلاثي الأبعاد غير الجارحة التي تم تقديمها إلى مجتمع البحث الطبي ، فإن التصوير المقطعي للترابط البصري (OCT) باعتباره تقنية صدى يشبه التصوير بالموجات فوق الصوتية . لا تستخدم تقنيات التصوير الطبي الأخرى ، مثل التصوير المقطعي المحوري المحوسب أو التصوير بالرنين المغناطيسي أو التصوير المقطعي بالإصدار البوزيتروني ، مبدأ تحديد موقع الصدى.[19]
تقتصر هذه التقنية على التصوير من 1 إلى 2 مم تحت السطح في الأنسجة البيولوجية ، لأنه في الأعماق الأكبر تكون نسبة الضوء الذي يتسرب دون تشت صغيرة جدًا بحيث لا يمكن اكتشافها. لا يلزم تحضير خاص لعينة بيولوجية ، ويمكن الحصول على صور "غير ملامسة" أو من خلال نافذة شفافة أو غشاء. من المهم أيضًا ملاحظة أن إخراج الليزر من الأدوات منخفض - يتم استخدام ضوء الأشعة تحت الحمراء القريب من الأشعة تحت الحمراء الآمنة للعين - وبالتالي لا يُحتمل حدوث أي ضرر للعينة.
النظرية
مبدأ التصوير المقطعي للترابط البصري هو الضوء الأبيض ، أو الترابط المنخفض ، قياس التداخل. يتكون الإعداد البصري عادةً من مقياس تداخل (الشكل 1 ، عادةً من نوع ميكلسون ) مع ترابط منخفض ، ومصدر ضوء ذو نطاق ترددي عريض. ينقسم الضوء إلى ذراع مرجعي وعينة ، على التوالي.
النطاق الزمني
في النطاق الزمني للتصوير المقطعي للترابط البصري ، يتغير طول مسار الذراع المرجعي بمرور الوقت (تتم ترجمة المرآة المرجعية طوليًا). من خصائص قياس التداخل للترابط المنخفض أن التداخل ، أي سلسلة الحواف المظلمة والمنيرة، لا يتحقق إلا عندما يكمن اختلاف المسار في طول تماسك مصدر الضوء. يسمى هذا التداخل بالارتباط التلقائي في مقياس التداخل المتماثل (كلا الذراعين لهما نفس الانعكاسية) ، أو الارتباط المتبادل في الحالة الشائعة. يتغير غلاف هذا التشكيل بتغير اختلاف طول المسار ، حيث تتوافق ذروة الغلاف مع مطابقة طول المسار.
يمكن التعبير عن تداخل حزمتين مترابطتين جزئيًا من حيث كثافة المصدر ، ، مثل
حيث يمثل نسبة تقسيم حزمة مقياس التداخل ، و تسمى الدرجة المعقدة من الترابط ، أي أن غلاف التداخل والناقل يعتمدان على مسح الذراع المرجعي أو التأخير الزمني ، والتي يكون استردادها أمرًا مهمًا في التصوير المقطعي لترابط البصري. نظرًا لتأثير بوابة الترابط لالتصوير المقطعي لترابط البصري ، يتم تمثيل درجة الترابط المعقدة كدالة غاوسية معبر عنها بـ[4]
حيث يمثل العرض الطيفي للمصدر في مجال التردد البصري ، و هو التردد البصري المركزي للمصدر. في المعادلة (2) ، الغلاف الغاوسي هو السعة المعدلة بواسطة حامل بصري. تمثل ذروة هذا المغلف موقع البنية المجهرية للعينة قيد الاختبار ، مع اتساع يعتمد على انعكاس السطح. يعود سبب الحامل البصري إلى تأثير دوپلر الناتج عن مسح ذراع واحد من مقياس التداخل ، ويتم التحكم في تردد هذا التعديل بواسطة سرعة المسح. لذلك ، فإن ترجمة ذراع واحد لمقياس التداخل لها وظيفتان ؛ يتم إجراء مسح عميق وحامل بصري لدوبلر متغير من خلال تغيير طول المسار. في التصوير المقطعي للترابط البصري ، يكون للناقل البصري للدوبلر المتغير تردد يتم التعبير عنه كـ
حيث هو التردد البصري المركزي للمصدر ، هي سرعة المسح لتغير طول المسار ، و هي سرعة الضوء.
يتم فصل الحزم المحورية والجانبية للتصوير المقطعي للترابط البصري عن بعضها البعض ؛ الأول هو ما يعادل طول تماسك مصدر الضوء والأخير هو وظيفة البصريات. يتم تعريف الدقة المحورية للتصوير المقطعي للترابط البصري على أنها
حيث و هما على التوالي الطول الموجي المركزي والعرض الطيفي لمصدر الضوء .[20]
نطاق التردد
في مجال (نطاق) التردد للتصوير المقطعي للترابط البصري (FD-OCT) يتم الحصول على تداخل النطاق العريض بواسطة أجهزة الكشف المنفصلة طيفيًا. نهجان شائعان هما التصوير المقطعي للترابط البصري والمجال الطيفي والمصدر المتغير (المزاح). يشفر المصدر المزاح للتصوير المقطعي للترابط البصري التردد البصري في الوقت المناسب بمصدر المسح الطيفي. يستخدم المجال الطيفي للتصوير المقطعي للترابط البصري كاشفًا مشتتًا ، مثل صفيف محزوز وكاشف خطي ، لفصل الأطوال الموجية المختلفة. نظرًا لعلاقة فورييه (نظرية وينر-خينتشين بين الارتباط التلقائي وكثافة القدرة الطيفية) ، يمكن حساب مسح العمق على الفور بواسطة تحويل فورييه من الأطياف المكتسبة ، دون حركة الذراع المرجعيي[21][22] تعمل هذه الميزة على تحسين سرعة التصوير بشكل كبير ، بينما تؤدي الخسائر المخفضة أثناء الفحص الفردي إلى تحسين نسبة الإشارة إلى الضجيج بما يتناسب مع عدد عناصر الكشف. يحد الكشف المتوازي عند نطاقات أطوال موجية متعددة من نطاق المسح ، بينما يحدد النطاق الترددي الطيفي الكامل الدقة المحورية.[23]
التشفير المكاني
يستخرج مجال التردد المشفر مكانيًا للتصوير المقطعي للترابط البصري (SEFD-OCT أو المجال الطيفي أو مجال فورييه للتصوير المقطعي للترابط البصري) المعلومات الطيفية عن طريق توزيع ترددات بصرية مختلفة على شريط كاشف (صفيف خط CCD أو CMOS) عبر عنصر مشتت (انظر الشكل 4). وبالتالي يمكن الحصول على معلومات مسح العمق الكامل في تعريض واحد. ومع ذلك ، يتم تقليل ميزة الإشارة إلى الضجيج الكبيرة لمجال فورييه للتصوير المقطعي للترابط البصري بسبب النطاق الديناميكي المنخفض لأجهزة الكشف الشريطية فيما يتعلق بالثنائيات الفردية الحساسة للضوء ، مما يؤدي إلى ميزة SNR (نسبة الإشارة إلى الضجيج ) بمقدار 10 ديسيبل بسرعات أعلى بكثير. هذه ليست مشكلة كبيرة عند العمل في 1300 نانومتر ، ومع ذلك ، لأن النطاق الديناميكي ليس مشكلة خطيرة في نطاق الطول الموجي هذا.[20]
تم العثور على عيوب هذه التقنية في الانخفاض القوي في نسبة الإشارة إلى الضجيج (SNR) ، والتي تتناسب مع المسافة من التأخير الصفري وتقليل من النوع -sinc للحساسية المعتمدة على العمق بسبب محدودية عرض خط الكشف. (يكتشف بكسل واحد جزءًا شبه مستطيل من نطاق تردد بصري بدلاً من تردد واحد ، ويؤدي تحويل فورييه إلى سلوك sinc (Z)). بالإضافة إلى ذلك ، لا توزع العناصر المشتتة في الكاشف الطيفي عادةً الضوء المتباعد بالتساوي في التردد على الكاشف ، ولكن في الغالب يكون لها اعتماد عكسي. لذلك ، يجب إعادة تشكيل الإشارة قبل المعالجة ، الأمر الذي لا يمكن أن يهتم بالاختلاف في عرض النطاق الترددي المحلي (البكسل) ، مما يؤدي إلى مزيد من التخفيض في جودة الإشارة. ومع ذلك ، فإن الانخفاض لا يمثل مشكلة خطيرة في تطوير الجيل الجديد من CCD أو مصفوفة الثنائي الضوئي مع عدد أكبر من وحدات البكسل.
يوفر الكشف عن الصفيفة غير المتجانسة الاصطناعية طريقة أخرى لهذه المشكلة دون الحاجة إلى التشتت العالي.
التشفير الزمني
يحاول مجال التردد الزمني المشفر التصوير المقطعي للترابط البصري (TEFD-التصوير المقطعي للترابط البصري أو التصوير المقطعي للترابط البصري للمصدر المزاح) الجمع بين بعض مزايا TD القياسي و SEFD-التصوير المقطعي للترابط البصري . هنا لا يتم ترميز المكونات الطيفية عن طريق الفصل المكاني ، ولكن يتم ترميزها في الوقت المناسب. يتم ترشيح أو توليد الطيف بخطوات تردد متتالية وحيدة وإعادة بنائها قبل تحويل فورييه. من خلال توفير مصدر ضوئي لمسح التردد (أي ليزر مسح التردد) ، يصبح الإعداد البصري (انظر الشكل 3) أبسط من SEFD ، ولكن يتم ترجمة مشكلة المسح بشكل أساسي من الذراع المرجعي TD-التصوير المقطعي للترابط البصري إلى مصدر ضوء TEFD-التصوير المقطعي للترابط البصري . تكمن الميزة هنا في تقنية الكشف عن نسبة الإشارة إلى الضجيج (SNR) العالية التي أثبتت جدواها ، بينما تحقق مصادر الليزر المجتذب نطاقات ترددية لحظية صغيرة جدًا (خطوط) عند ترددات عالية جدًا (20-200 كيلو هرتز). العيوب هي اللاخطية في الطول الموجي (خاصة عند ترددات المسح العالية) ، وتوسيع عرض الخط عند الترددات العالية والحساسية العالية لحركات هندسة المسح أو العينة (أقل من نطاق نانومتر ضمن خطوات التردد المتتالية).
التصوير المقطعي للترابط البصري كامل النطاق
طور فريق كلود بوكارا أسلوب التصوير في التصوير المقطعي للترابط البصري الصدغي في عام 1998,[24] مع الحصول على الصور بدون مسح الحزمة. في هذه التقنية التي تسمى التصوير المقطعي للترابط البصري كامل المجال (FF-OCT) ، على عكس تقنيات التصوير المقطعي للترابط البصري الأخرى التي تحصل على مقاطع عرضية للعينة ، تكون الصور هنا "en-face" ، أي مثل صور الفحص المجهري الكلاسيكي: متعامدة مع شعاع الضوء للإضاءة.[25]
بتعبير أدق ، يتم إنشاء صور قياس التداخل بواسطة مقياس تداخل ميكلسون حيث يتغير اختلاف طول المسار بواسطة مكون كهربائي سريع (عادةً ما تكون مرآة بيزو في الذراع المرجعي). يتم دمج هذه الصور التي تم الحصول عليها بواسطة كاميرا CCD في المعالجة اللاحقة (أو عبر الإنترنت) بواسطة طريقة قياس تداخل إزاحة الطور ، حيث يتم عادةً الحصول على صورتين أو أربع صور لكل فترة تعديل ، اعتمادًا على الخوارزمية المستخدمة.[26][27] في الآونة الأخيرة ، تم تطوير الأساليب التي تسمح بالتصوير السريع بلقطة واحدة لالتقاط صور متعددة متغيرة الطور في وقت واحد مطلوبة لإعادة الإعمار ، باستخدام كاميرا واحدة.[28] يقتصر OCM على نطاق زمني أحادي اللقطة على معدل إطار الكاميرا والإضاءة المتاحة.
يتم إنتاج الصور المقطعية "en-face" بواسطة إضاءة واسعة المجال ، مكفولة بتكوين Linnik لمقياس تداخل ميكلسون حيث يتم استخدام كائن مجهر في كلا الذراعين. علاوة على ذلك ، بينما يجب أن يظل التماسك الزمني للمصدر منخفضًا كما هو الحال في التصوير المقطعي للترابط البصري الكلاسيكي (أي طيف واسع) ، يجب أيضًا أن يكون التماسك المكاني منخفضًا لتجنب التداخلات الطفيلية (أي مصدر بحجم كبير.[29]
حقل الخط (متحد البؤر) للتصوير المقطعي للترابط البصري
التصوير المقطعي البصري متحد البؤر للمجال الخطي (LC-OCT) هو تقنية تصوير تعتمد على مبدأ التصوير المقطعي للترابط البصري للمجال الزمني مع إضاءة الخط باستخدام ليزر عريض النطاق واكتشاف الخط باستخدام كاميرا مسح ضوئي.[30] تنتج LC-OCT عمليات المسح الضوئي B في الوقت الفعلي من عمليات المسح A المتعددة التي تم الحصول عليها بالتوازي. يمكن أيضًا الحصول على صور En face عن طريق مسح خط الإضاءة بشكل جانبي..[31] يتم ضبط التركيز بشكل مستمر أثناء مسح عمق العينة ، باستخدام مجهر ذو فتحة عددية عالية (NA) بهدف التصوير بدقة جانبية عالية. باستخدام ليزر فائق التوصيل كمصدر للضوء ، استبانة مكانية شبه متناحية تبلغ ~ 1ميكرومتر يتم تحقيقها بطول موجي مركزي يبلغ 800 ~نانومتر. من ناحية أخرى ، ينتج عن إضاءة الخط واكتشافه ، جنبًا إلى جنب مع استخدام هدف مجهر عالي NA ، بوابة متحد البؤر تمنع معظم الضوء المنتشر الذي لا يساهم في اكتشاف الإشارة بواسطة الكاميرا. هذه البوابة متحد البؤر ، التي لا توجد في تقنية OCT ذات المجال الكامل ، تمنح LC-OCT ميزة من حيث حساسية الكشف والاختراق في الوسائط شديدة التشتت مثل أنسجة الجلد.[32] حتى الآن ، تم استخدام هذه التقنية بشكل أساسي لتصوير الجلد في مجالات طب الجلد والتجميل.[33]
مخططات المسح
سيؤدي تركيز شعاع الضوء إلى نقطة على سطح العينة قيد الاختبار ، وإعادة توحيد الضوء المنعكس مع المرجع ، إلى إنتاج مخطط تداخل مع معلومات العينة المقابلة لمسح A واحد (المحور Z فقط). يمكن إجراء مسح للعينة إما عن طريق مسح الضوء على العينة ، أو عن طريق تحريك العينة قيد الاختبار. سينتج عن المسح الخطي مجموعة بيانات ثنائية الأبعاد تتوافق مع صورة مقطعية (مسح محاور XZ) ، بينما يحقق مسح المنطقة مجموعة بيانات ثلاثية الأبعاد تتوافق مع صورة حجمية (مسح محاور XYZ).
نقطة واحدة
Sيجب أن تقوم الأنظمة التي تعتمد على نقطة واحدة أو متحد البؤر أو مجال وقت الانتقال في التصوير المقطعي للترابط البصري ، بمسح العينة في بعدين جانبيين وإعادة بناء صورة ثلاثية الأبعاد باستخدام معلومات العمق التي تم الحصول عليها عن طريق بوابة التماسك من خلال ذراع مرجعي للمسح المحوري (الشكل 2) . تم تنفيذ المسح الجانبي ثنائي الأبعاد كهروميكانيكيًا عن طريق تحريك العينة[22]باستخدام مرحلة الترجمة ، واستخدام ماسح ضوئي للنظام الميكانيكي الكهروميكانيكي الجديد.[34]
موازي
تم استخدام التصوير المقطعي للترابط البصري الموازي أو النطاق الكامل باستخدام كاميرا جهاز مقترن بالشحن (CCD) حيث تكون العينة مضاءة بالمجال الكامل ويتم تصوير الوجه باستخدام CCD ، وبالتالي القضاء على المسح الجانبي الكهروميكانيكي. من خلال تحريك المرآة المرجعية وتسجيل صور متتالية للوجه ، يمكن إعادة بناء التمثيل ثلاثي الأبعاد. تم توضيح التصوير المقطعي للترابط البصري ثلاثي الأبعاد باستخدام كاميرا CCD في تقنية متدرجة الطور,[35] باستخدام إزاحة الطور الهندسي باستخدام مقياس تداخل Linnik,[36] باستخدام زوج من أجهزة CCD واكتشاف التغاير,[37] وفي مقياس تداخل Linnik مع مرآة مرجعية متذبذبة ومرحلة ترجمة محورية.[38] من الأمور المركزية لنهج CCD ضرورة وجود أجهزة CCD سريعة جدًا أو توليد ناقل منفصل عن المرآة المرجعية المتدرجة لتتبع ناقل التصوير المقطعي للترابط البصري عالي التردد
المصفوفة الكاشفة الذكية
مصفوفة كاشف ذكية ثنائية الأبعاد ، مُصنَّعة باستخدام أشباه الموصلات المعدنية (CMOS) التكميلية 2 ميكرومتر لإثبات TD-OCT كامل النطاق[39] يتميز بإعداد بصري غير معقد (الشكل 3) ، كل بكسل من 58x58 بكسل من المصفوفة الكاشفة الذكية يعمل كديود ضوئي فردي ويتضمن دارة إزالة تشكيل الأجهزة الخاصة به.
تطبيقات مختارة
التصوير المقطعي للترابط البصري هو تقنية تصوير طبي راسخة ويستخدم في العديد من التخصصات الطبية بما في ذلك طب العيون وطب القلب ، ويستخدم على نطاق واسع في تطبيقات البحوث العلمية الأساسية.
طب العيون
يستخدم التصوير المقطعي للترابط البصري العيني (OCT) بكثافة من قبل أطباء العيون ومصححي البصر للحصول على صور عالية الدقة لشبكية العين وقطعة العين الأمامية . نظرًا لقدرة التصوير المقطعي للترابط البصري على إظهار المقاطع العرضية لطبقات الأنسجة بدقة ميكرومتر ، يوفر التصوير المقطعي للترابط البصري طريقة مباشرة لتقييم التنظيم الخلوي ، وسلامة المستقبلات الضوئية,[40][41][42][43] وسمك المحور العصبي في الزرق,[44] الضمور البقعي,[45] الوذمة البقعية السكرية,[46] التصلب المتعدد[47] وأمراض العيون الأخرى أو الأمراض الجهازية التي لها علامات بصرية.[48] بالإضافة إلى ذلك ، يستفيد أطباء العيون من التصوير المقطعي للترابط البصري لتقييم صحة الأوعية الدموية في شبكية العين عبر تقنية تسمى تصوير الأوعية المقطعي للترابط البصري(OCTA).[49] في جراحة العيون ، وخاصة جراحة الشبكية ، يمكن تركيب التصوير المقطعي للترابط البصري على المجهر. يُطلق على هذا النظام اسم التصوير المقطعي للترابط البصري أثناء الجراحة (iOCT) ويوفر الدعم أثناء الجراحة بفوائد سريرية.[50]
تطبيقات أمراض القلب والأوعية الدموية
في إعداد أمراض القلب ، يتم استخدام التصوير المقطعي للترابط البصري (OCT) لتصوير الشرايين التاجية من أجل تصور شكل تجويف جدار الوعاء والبنية المجهرية بدقة أعلى 10 مرات من الطرائق الأخرى الموجودة مثل الموجات فوق الصوتية داخل الأوعية ، وتصوير الأوعية بالأشعة السينية ( التصوير المقطعي البصري داخل التاجي ). بالنسبة لهذا النوع من التطبيقات ، 1 ملم تقريبًا تستخدم قثاطير الألياف الضوئية بقطر ملم للوصول إلى تجويف الشريان من خلال التدخلات شبه الجارحة مثل التدخلات التاجية عن طريق الجلد .
تم الإ عن أول إيضاح للتصوير المقطعي للترابط البصري بالمنظار في عام 1997 ، من قبل الباحثين في مختبر جيمس فوجيموتو في معهد ماساتشوستس للتكنولوجيا ، بما في ذلك البروفيسور. جيليرمو جيمس تيرني والبروفيسور. بريت بوما.[51] تم تسويق أول قسطرة ونظام تصوير TD-OCT بواسطة LightLab Imaging، Inc. ، وهي شركة مقرها ماساتشوستس في عام 2006. تم الإبلاغ عن أول دراسة تصوير FD-OCT بواسطة مختبر البروفيسور. جيليرمو جيه تيرني والبروفيسور. بريت بوما ومقره في مستشفى ماساتشوستس العام في عام 2008.[52] تم تقديم FD-OCT داخل الأوعية لأول مرة في السوق في عام 2009 بواسطة LightLab Imaging، Inc..[53] وأطلقت شركة تيرومو حلًا ثانيًا لتصوير الشريان التاجي في عام 2012. مكنت سرعة التصوير العالية لـ FD-OCT من التبني الواسع لتقنية التصوير هذه لتصوير الشريان التاجي. تشير التقديرات إلى أن أكثر من 100000 حالة تصوير للشريان التاجي يتم إجراؤها سنويًا ، وأن السوق يزداد بنسبة 20 ٪ تقريبًا كل عام.[54]
تم فحص التصوير المقطعي للترابط البصري داخل الأوعية الدموية لاستخدامه في تطبيقات الأوعية الدموية العصبية أيضًا ، بما في ذلك التصوير لتوجيه العلاج داخل الأوعية الدموية للسكتة الدماغية وتمدد الأوعية الدموية في الدماغ[55] اقتصر الاستخدام السريري على التشريح القريب داخل الجمجمة للمريض ذي التعرج المحدود ، مما يُظهر إمكانات التصوير المقطعي المحوسب لتصوير أمراض الأوعية الدموية العصبية. [56] تم اقتراح تصميم قسطرة تصويرالتصوير المقطعي للترابط البصري داخل الأوعية المصممة للاستخدام في تشريح الأوعية الدموية المتعرجة في عام 2020.[57]
تضمنت التطورات الإضافية في التصوير المقطعي للترابط البصري داخل الأوعية الدمج مع طرائق التصوير البصري الأخرى (التصوير متعدد الوسائط). تم دمج التصوير المقطعي للترابط البصري مع التصوير الجزيئي الفلوري لتعزيز قدرته على اكتشاف المعلومات الجزيئية / الوظيفية والصرفية للأنسجة في نفس الوقت.[58] بطريقة مماثلة ، تم أيضًا الجمع بين التحليل الطيفي للأشعة تحت الحمراء القريبة..
علم الأورام
تم تطبيق التصوير المقطعي للترابط البصري بالمنظار للكشف عن وتشخيص السرطان والآفات محتملة التسرطن ، مثل مريء باريت وخلل التنسج المريئي..[59]
طب الجلد
يعود أول استخدام للتصوير المقطعي للترابط البصري في الأمراض الجلدية إلى عام 1997..[60] منذ ذلك الحين ، تم تطبيق التصوير المقطعي للترابط البصري لتشخيص الآفات الجلدية المختلفة بما في ذلك السرطانات.[61][62][63] ومع ذلك ، فإن تشخيص الميلانوما باستخدام التصوير المقطعي للترابط البصري التقليدي أمر صعب ، خاصة بسبب عدم كفاية دقة التصوير.[64] تقنيات التصوير المقطعي للترابط البصري الناشئة عالية الدقة مثل LC-OCT لديها القدرة على تحسين عملية التشخيص السريري ، مما يسمح بالكشف المبكر عن أورام الجلد الخبيثة - بما في ذلك الورم الميلانيني - وتقليل عدد الاستئصال الجراحي للآفات الحميدة.[65] تشمل مجالات التطبيق الواعدة الأخرى تصوير الآفات حيث يكون الاستئصال خطر أو مستحيل وتوجيه التدخلات الجراحية من خلال تحديد حواف الورم..
طب الاسنان
تمكن الباحثون في جامعة طوكيو للطب وطب الأسنان من اكتشاف آفات البقع البيضاء في المينا حول وأسفل الأقواس التقويمية باستخدام مصدر للتصوير المقطعي للترابط البصري مزاح.[66]
تطبيقات الابحاث
استخدم الباحثون التصوير المقطعي للترابط البصري لإنتاج صور مفصلة لأدمغة الفئران ، من خلال "نافذة" مصنوعة من الزركونيا تم تعديلها لتكون شفافة ومزروعة في الجمجمة.[67] التصوير المقطعي للتماسك البصري قابل للتطبيق ويستخدم بشكل متزايد في التطبيقات الصناعية ، مثل الاختبار الغير التدميري (NDT) ، وقياسات سمك المادة,[68] وعلى وجه الخصوص رقائق السيليكون الرقيقة[69][70]وقياسات سمك رقائق أشباه الموصلات المركبة[71][72] توصيف خشونة السطح والتصوير السطحي والمقطع العرضي[73][74] وقياسات فقدان الحجم. يمكن استخدام أنظمة التصوير المقطعي للترابط البصري ذات التغذية الراجعة للتحكم في عمليات التصنيع. من خلال الحصول على البيانات عالية السرعة,[75] ودقة الوضوح شبه الميكرون ، يمكن تكييف التصوير المقطعي للترابط البصري لأداء كل من الخط الداخلي والغير متصل..[76] نظرًا للكم الهائل من الحبوب المنتجة ، يوجد مجال تطبيق مثير للاهتمام في صناعة المستحضرات الصيدلانية للتحكم في طلاء الأقراص.[77] أنظمة التصوير المقطعي للترابط البصري القائمة على الألياف قابلة للتكيف بشكل خاص مع البيئات الصناعية..[78] يمكن لهذه الأجهزة الوصول وفحص المساحات الداخلية التي يصعب الوصول إليها,[79] وتكون قادرة على العمل في بيئات معادية - سواء كانت مشعة أو مبردة أو شديدة الحرارة.[80] Nجري حاليًا تطوير تقنيات جديدة للتشخيص والتصوير الطبي الحيوي البصري لحل المشكلات في علم الأحياء والطب.[81] اعتبارًا من عام 2014 ، تم إجراء محاولات لاستخدام التصوير المقطعي البصري لتحديد قنوات الجذر في الأسنان ، وتحديداً القناة في الضرس الفكي العلوي ، ومع ذلك ، لا يوجد فرق مع الأساليب الحالية لمجهر الأسنان الجراحي.[82][83][بحاجة لمصدر غير رئيسي] نجح البحث الذي تم إجراؤه في عام 2015 في استخدام الهاتف الذكي كمنصة التصوير المقطعي للترابط البصري ، على الرغم من أنه لا يزال هناك الكثير من العمل الذي يتعين القيام به قبل أن تصبح هذه المنصة قابلة للتطبيق تجاريًا.[84]
انظر أيضاً
المصادر
- ^ Bezerra HG, Costa MA, Guagliumi G, Rollins AM, Simon DI (November 2009). "Intracoronary optical coherence tomography: a comprehensive review clinical and research applications". JACC. Cardiovascular Interventions. 2 (11): 1035–46. doi:10.1016/j.jcin.2009.06.019. PMC 4113036. PMID 19926041.
- ^ Chua S (2015). "High-Definition Optical Coherence Tomography for the Study of Evolution of a Disease" (PDF). Dermatology Bulletin. 26 (1): 2–3. Retrieved 28 May 2015.
- ^ Fercher AF, Roth E (15 September 1986). Mueller GJ (ed.). "Ophthalmic laser interferometry". Proc. SPIE. Optical Instrumentation for Biomedical Laser Applications. 658: 48–51. Bibcode:1986SPIE..658...48F. doi:10.1117/12.938523. S2CID 122883903.
- ^ أ ب ت Fercher AF, Mengedoht K, Werner W (March 1988). "Eye-length measurement by interferometry with partially coherent light". Optics Letters. 13 (3): 186–8. Bibcode:1988OptL...13..186F. doi:10.1364/OL.13.000186. PMID 19742022.
- ^ (12–16 August 1990) "Ophthalmic interferometry".: 221–228.
- ^ Naohiro Tanno, Tsutomu Ichikawa, Akio Saeki: "Lightwave Reflection Measurement," Japanese Patent # 2010042 (1990) (Japanese Language)
- ^ (1991) "Backscattering Optical Heterodyne Tomography" in 14th Laser Sensing Symposium..
- ^ Huang D, Swanson EA, Lin CP, Schuman JS, Stinson WG, Chang W, et al. (November 1991). "Optical coherence tomography". Science. 254 (5035): 1178–81. Bibcode:1991Sci...254.1178H. doi:10.1126/science.1957169. PMC 4638169. PMID 1957169.
- ^ Zysk AM, Nguyen FT, Oldenburg AL, Marks DL, Boppart SA (2007). "Optical coherence tomography: a review of clinical development from bench to bedside". Journal of Biomedical Optics. 12 (5): 051403. Bibcode:2007JBO....12e1403Z. doi:10.1117/1.2793736. PMID 17994864. S2CID 20621284.
- ^ Fercher AF, Hitzenberger CK, Drexler W, Kamp G, Sattmann H (July 1993). "In vivo optical coherence tomography". American Journal of Ophthalmology. 116 (1): 113–4. doi:10.1016/S0002-9394(14)71762-3. PMID 8328536.
- ^ Swanson EA, Izatt JA, Hee MR, Huang D, Lin CP, Schuman JS, et al. (November 1993). "In vivo retinal imaging by optical coherence tomography". Optics Letters. 18 (21): 1864–6. Bibcode:1993OptL...18.1864S. doi:10.1364/OL.18.001864. PMID 19829430. S2CID 21218566.
- ^ Drexler W, Morgner U, Ghanta RK, Kärtner FX, Schuman JS, Fujimoto JG (April 2001). "Ultrahigh-resolution ophthalmic optical coherence tomography". Nature Medicine. 7 (4): 502–7. doi:10.1038/86589. PMC 1950821. PMID 11283681.
- ^ Kaufman SC, Musch DC, Belin MW, Cohen EJ, Meisler DM, Reinhart WJ, et al. (February 2004). "Confocal microscopy: a report by the American Academy of Ophthalmology". Ophthalmology. 111 (2): 396–406. doi:10.1016/j.ophtha.2003.12.002. PMID 15019397.
- ^ Riederer SJ (2000). "Current technical development of magnetic resonance imaging". IEEE Engineering in Medicine and Biology Magazine. 19 (5): 34–41. doi:10.1109/51.870229. PMID 11016028.
- ^ M. Born; E. Wolf (2000). Principles of Optics: Electromagnetic Theory of Propagation, Interference, and Diffraction of Light. Cambridge University Press. ISBN 978-0-521-78449-8.
- ^ Fujimoto JG, Pitris C, Boppart SA, Brezinski ME (2000). "Optical coherence tomography: an emerging technology for biomedical imaging and optical biopsy". Neoplasia. 2 (1–2): 9–25. doi:10.1038/sj.neo.7900071. PMC 1531864. PMID 10933065.
- ^ Michelessi M, Lucenteforte E, Oddone F, Brazzelli M, Parravano M, Franchi S, et al. (November 2015). "Optic nerve head and fibre layer imaging for diagnosing glaucoma". The Cochrane Database of Systematic Reviews (11): CD008803. doi:10.1002/14651858.CD008803.pub2. PMC 4732281. PMID 26618332.
- ^ Drexler W, Morgner U, Kärtner FX, Pitris C, Boppart SA, Li XD, et al. (September 1999). "In vivo ultrahigh-resolution optical coherence tomography". Optics Letters. OSA. 24 (17): 1221–3. doi:10.1364/bio.1999.jwa2. PMID 18073990.
- ^ "Optical Coherence Tomography provides better resolution than an MRI and Helps Diagnose Retina & Corneal Disease and Glaucoma, Part II". mastereyeassociates.com. mastereyeassociates. June 13, 2017. Retrieved June 13, 2017.
- ^ أ ب Garg A (2014). Anterior & Posterior Segment OCT: Current Technology & Future Applications, 1st edition.
- ^ Schmitt JM (1999). "Optical coherence tomography (OCT): a review". IEEE Journal of Selected Topics in Quantum Electronics. 5 (4): 1205–1215. Bibcode:1999IJSTQ...5.1205S. doi:10.1109/2944.796348. S2CID 6102146.
- ^ أ ب Fercher AF, Hitzenberger CK, Kamp G, El-Zaiat SY (1995). "Measurement of intraocular distances by backscattering spectral interferometry". Optics Communications. 117 (1–2): 43–48. Bibcode:1995OptCo.117...43F. doi:10.1016/0030-4018(95)00119-S.
- ^ de Boer JF, Leitgeb R, Wojtkowski M (July 2017). "Twenty-five years of optical coherence tomography: the paradigm shift in sensitivity and speed provided by Fourier domain OCT [Invited]". Biomedical Optics Express. 8 (7): 3248–3280. doi:10.1364/BOE.8.003248. PMC 5508826. PMID 28717565.
- ^ Beaurepaire E, Boccara AC, Lebec M, Blanchot L, Saint-Jalmes H (February 1998). "Full-field optical coherence microscopy". Optics Letters. 23 (4): 244–6. Bibcode:1998OptL...23..244B. doi:10.1364/ol.23.000244. PMID 18084473.
- ^ Dubois A, Boccara C (October 2006). "[Full-field OCT]". Médecine/Sciences (in الفرنسية). 22 (10): 859–64. doi:10.1051/medsci/20062210859. PMID 17026940.
- ^ Dubois A, Moneron G, Boccara C (2006). "Thermal-light full-field optical coherence tomography in the 1.2 micron wavelength region" (PDF). Optics Communications (in الإنجليزية). 266 (2): 738–743. Bibcode:2006OptCo.266..738D. doi:10.1016/j.optcom.2006.05.016.
- ^ Boccara AC, Harms F, Latrive A (2013). "Full-field OCT: a non-invasive tool for diagnosis and tissue selection". SPIE Newsroom (in الإنجليزية). doi:10.1117/2.1201306.004933. S2CID 123478275.
- ^ Žurauskas, Mantas; Iyer, Rishyashring; Boppart, Stephen (2021-01-15). "Simultaneous 4-phase-shifted full-field optical coherence microscopy". Biomedical Optics Express. The Optical Society. doi:10.1364/boe.417183. ISSN 2156-7085.
- ^ Boccara AC, Dubois A (2013). "Optical Coherence Tomography". Optics in Instruments (in الإنجليزية). pp. 101–123. doi:10.1002/9781118574386.ch3. ISBN 9781118574386.
- ^ Dubois A, Levecq O, Azimani H, Davis A, Ogien J, Siret D, Barut A (December 2018). "Line-field confocal time-domain optical coherence tomography with dynamic focusing". Optics Express. 26 (26): 33534–33542. Bibcode:2018OExpr..2633534D. doi:10.1364/OE.26.033534. PMID 30650800.
- ^ Ogien J, Levecq O, Azimani H, Dubois A (March 2020). "in vivo". Biomedical Optics Express. 11 (3): 1327–1335. doi:10.1364/BOE.385303. PMC 7075601. PMID 32206413.
- ^ Chen Y, Huang SW, Aguirre AD, Fujimoto JG (July 2007). "High-resolution line-scanning optical coherence microscopy". Optics Letters. 32 (14): 1971–3. Bibcode:2007OptL...32.1971C. doi:10.1364/OL.32.001971. PMID 17632613.
- ^ Pedrazzani M, Breugnot J, Rouaud-Tinguely P, Cazalas M, Davis A, Bordes S, et al. (May 2020). "Comparison of line-field confocal optical coherence tomography images with histological sections: Validation of a new method for in vivo and non-invasive quantification of superficial dermis thickness". Skin Research and Technology. 26 (3): 398–404. doi:10.1111/srt.12815. PMID 31799766. S2CID 208622348.
- ^ Yeow JT, Yang VX, Chahwan A, Gordon ML, Qi B, Vitkin IA, Wilson BC, Goldenberg AA (2005). "Micromachined 2-D scanner for 3-D optical coherence tomography". Sensors and Actuators A: Physical. 117 (2): 331–340. doi:10.1016/j.sna.2004.06.021.
- ^ Dunsby C, Gu Y, French P (January 2003). "Single-shot phase-stepped wide-field coherencegated imaging". Optics Express. 11 (2): 105–15. Bibcode:2003OExpr..11..105D. doi:10.1364/OE.11.000105. PMID 19461712.
- ^ Roy M, Svahn P, Cherel L, Sheppard CJ (2002). "Geometric phase-shifting for low-coherence interference microscopy". Optics and Lasers in Engineering. 37 (6): 631–641. Bibcode:2002OptLE..37..631R. doi:10.1016/S0143-8166(01)00146-4.
- ^ Akiba M, Chan KP, Tanno N (May 2003). "Full-field optical coherence tomography by two-dimensional heterodyne detection with a pair of CCD cameras". Optics Letters. 28 (10): 816–8. Bibcode:2003OptL...28..816A. doi:10.1364/OL.28.000816. PMID 12779156.
- ^ Dubois A, Vabre L, Boccara AC, Beaurepaire E (February 2002). "High-resolution full-field optical coherence tomography with a Linnik microscope". Applied Optics. 41 (4): 805–12. Bibcode:2002ApOpt..41..805D. doi:10.1364/AO.41.000805. PMID 11993929.
- ^ Bourquin S, Seitz P, Salathé RP (April 2001). "Optical coherence topography based on a two-dimensional smart detector array". Optics Letters. 26 (8): 512–4. Bibcode:2001OptL...26..512B. doi:10.1364/OL.26.000512. PMID 18040369.
- ^ "The ABCs of OCT". Review of Optometry.
- ^ Sherman J (June 2009). "Photoreceptor integrity line joins the nerve fiber layer as key to clinical diagnosis". Optometry. 80 (6): 277–8. doi:10.1016/j.optm.2008.12.006. PMID 19465337.
- ^ "Outer Retinal Layers as Predictors of Vision Loss". Review of Ophthalmology.
- ^ Cuenca N, Ortuño-Lizarán I, Pinilla I (March 2018). "Cellular Characterization of OCT and Outer Retinal Bands Using Specific Immunohistochemistry Markers and Clinical Implications". Ophthalmology. 125 (3): 407–422. doi:10.1016/j.ophtha.2017.09.016. hdl:10045/74474. PMID 29037595.
- ^ Grewal DS, Tanna AP (March 2013). "Diagnosis of glaucoma and detection of glaucoma progression using spectral domain optical coherence tomography". Current Opinion in Ophthalmology. 24 (2): 150–61. doi:10.1097/ICU.0b013e32835d9e27. PMID 23328662. S2CID 39039199.
- ^ Keane PA, Patel PJ, Liakopoulos S, Heussen FM, Sadda SR, Tufail A (September 2012). "Evaluation of age-related macular degeneration with optical coherence tomography". Survey of Ophthalmology. 57 (5): 389–414. doi:10.1016/j.survophthal.2012.01.006. PMID 22898648.
- ^ Virgili G, Menchini F, Casazza G, Hogg R, Das RR, Wang X, Michelessi M (January 2015). "Optical coherence tomography (OCT) for detection of macular oedema in patients with diabetic retinopathy". The Cochrane Database of Systematic Reviews. 1: CD008081. doi:10.1002/14651858.CD008081.pub3. PMC 4438571. PMID 25564068.
- ^ Dörr J, Wernecke KD, Bock M, Gaede G, Wuerfel JT, Pfueller CF, et al. (April 2011). "Association of retinal and macular damage with brain atrophy in multiple sclerosis". PLOS ONE. 6 (4): e18132. Bibcode:2011PLoSO...618132D. doi:10.1371/journal.pone.0018132. PMC 3072966. PMID 21494659.
{{cite journal}}: CS1 maint: unflagged free DOI (link)
- ^ Aik Kah T (2018). "CuRRL Syndrome: A Case Series" (PDF). Acta Scientific Ophthalmology. 1: 9–13 – via https://actascientific.com/ASOP/pdf/ASOP-01-0016.pdf.
{{cite journal}}: External link in|via= - ^ Kashani AH, Chen CL, Gahm JK, Zheng F, Richter GM, Rosenfeld PJ, et al. (September 2017). "Optical coherence tomography angiography: A comprehensive review of current methods and clinical applications". Progress in Retinal and Eye Research. 60: 66–100. doi:10.1016/j.preteyeres.2017.07.002. PMC 5600872. PMID 28760677.
- ^ Ehlers, Justis P.; Tao, Yuankai K.; Srivastava, Sunil K. (May 2014). "The Value of Intraoperative OCT Imaging in Vitreoretinal Surgery". Current Opinion in Ophthalmology. 25 (3): 221–227. doi:10.1097/ICU.0000000000000044. ISSN 1040-8738. PMC 4119822. PMID 24614147.
- ^ Tearney GJ, Brezinski ME, Bouma BE, Boppart SA, Pitris C, Southern JF, Fujimoto JG (June 1997). "In vivo endoscopic optical biopsy with optical coherence tomography". Science. 276 (5321): 2037–9. doi:10.1126/science.276.5321.2037. PMID 9197265. S2CID 43035300.
- ^ Tearney GJ, Waxman S, Shishkov M, Vakoc BJ, Suter MJ, Freilich MI, et al. (November 2008). "Three-dimensional coronary artery microscopy by intracoronary optical frequency domain imaging". JACC. Cardiovascular Imaging. 1 (6): 752–61. doi:10.1016/j.jcmg.2008.06.007. PMC 2852244. PMID 19356512.
- ^ "LightLab launches FD-OCT in Europe". Retrieved 9 September 2016.
- ^ Swanson E (13 June 2016). "Optical Coherence Tomography: Beyond better clinical care: OCT's economic impact". BioOptics World. Retrieved 9 September 2016.
- ^ Chen CJ, Kumar JS, Chen SH, Ding D, Buell TJ, Sur S, et al. (April 2018). "Optical Coherence Tomography: Future Applications in Cerebrovascular Imaging". Stroke. 49 (4): 1044–1050. doi:10.1161/STROKEAHA.117.019818. PMID 29491139.
- ^ Xu X, Li M, Liu R, Yin Q, Shi X, Wang F, et al. (August 2020). "Optical coherence tomography evaluation of vertebrobasilar artery stenosis: case series and literature review". Journal of NeuroInterventional Surgery. 12 (8): 809–813. doi:10.1136/neurintsurg-2019-015660. PMID 32066569. S2CID 211159079.
- ^ Ughi GJ, Marosfoi MG, King RM, Caroff J, Peterson LM, Duncan BH, et al. (July 2020). "A neurovascular high-frequency optical coherence tomography system enables in situ cerebrovascular volumetric microscopy". Nature Communications. 11 (1): 3851. Bibcode:2020NatCo..11.3851U. doi:10.1038/s41467-020-17702-7. PMC 7395105. PMID 32737314.
- ^ Ughi GJ, Wang H, Gerbaud E, Gardecki JA, Fard AM, Hamidi E, et al. (November 2016). "Clinical Characterization of CoronaryAtherosclerosis With Dual-Modality OCTand Near-Infrared Autofluorescence Imaging". JACC. Cardiovascular Imaging. 9 (11): 1304–1314. doi:10.1016/j.jcmg.2015.11.020. PMC 5010789. PMID 26971006.
- ^ "Next-gen OCT for the esophagus". BioOptics World. 1 May 2013. Retrieved 9 September 2016.
- ^ Welzel J, Lankenau E, Birngruber R, Engelhardt R (December 1997). "Optical coherence tomography of the human skin". Journal of the American Academy of Dermatology. 37 (6): 958–63. doi:10.1016/S0190-9622(97)70072-0. PMID 9418764.
- ^ Boone MA, Norrenberg S, Jemec GB, Del Marmol V (October 2012). "Imaging of basal cell carcinoma by high-definition optical coherence tomography: histomorphological correlation. A pilot study". The British Journal of Dermatology. 167 (4): 856–64. doi:10.1111/j.1365-2133.2012.11194.x. PMID 22862425. S2CID 24965088.
- ^ Coleman AJ, Richardson TJ, Orchard G, Uddin A, Choi MJ, Lacy KE (February 2013). "Histological correlates of optical coherence tomography in non-melanoma skin cancer". Skin Research and Technology. 19 (1): 10–9. doi:10.1111/j.1600-0846.2012.00626.x. PMID 22738357. S2CID 26084419.
- ^ Ulrich M, von Braunmuehl T, Kurzen H, Dirschka T, Kellner C, Sattler E, et al. (August 2015). "The sensitivity and specificity of optical coherence tomography for the assisted diagnosis of nonpigmented basal cell carcinoma: an observational study". The British Journal of Dermatology. 173 (2): 428–35. doi:10.1111/bjd.13853. PMID 25904111.
- ^ Levine A, Wang K, Markowitz O (October 2017). "Optical Coherence Tomography in the Diagnosis of Skin Cancer". Dermatologic Clinics. 35 (4): 465–488. doi:10.1016/j.det.2017.06.008. PMID 28886803.
- ^ Dubois A, Levecq O, Azimani H, Siret D, Barut A, Suppa M, et al. (October 2018). "Line-field confocal optical coherence tomography for high-resolution noninvasive imaging of skin tumors" (PDF). Journal of Biomedical Optics. 23 (10): 106007. Bibcode:2018JBO....23j6007D. doi:10.1117/1.JBO.23.10.106007. PMID 30353716. S2CID 53023955.
 This article contains quotations from this source, which is available under the Creative Commons Attribution 3.0 Unported (CC BY 3.0) license.
This article contains quotations from this source, which is available under the Creative Commons Attribution 3.0 Unported (CC BY 3.0) license.
- ^ Velusamy P, Shimada Y, Kanno Z, Ono T, Tagami J (February 2019). "Optical evaluation of enamel white spot lesions around orthodontic brackets using swept-source optical coherence tomography (SS-OCT): An in vitro study". Dental Materials Journal. 38 (1): 22–27. doi:10.4012/dmj.2017-262. PMID 30158348.
- ^ Damestani Y, Reynolds CL, Szu J, Hsu MS, Kodera Y, Binder DK, et al. (November 2013). "Transparent nanocrystalline yttria-stabilized-zirconia calvarium prosthesis". Nanomedicine. 9 (8): 1135–8. doi:10.1016/j.nano.2013.08.002. PMID 23969102.
{{cite journal}}: Unknown parameter|lay-date=ignored (help); Unknown parameter|lay-source=ignored (help); Unknown parameter|lay-url=ignored (help) - ^ {{{1}}} patent {{{2}}}.
- ^ Walecki WJ, Szondy F (2008). Novak EL, Wolfgang O, Gorecki C (eds.). "Integrated quantum efficiency, reflectance, topography and stress metrology for solar cell manufacturing". Proc. SPIE. Interferometry XIV: Applications. 7064: 70640A. Bibcode:2008SPIE.7064E..0AW. doi:10.1117/12.797541. S2CID 120257179.
- ^ Walecki WJ, Lai K, Pravdivtsev A, Souchkov V, Van P, Azfar T, Wong T, Lau SH, Koo A (2005). Tanner DM, Ramesham R (eds.). "Low-coherence interferometric absolute distance gauge for study of MEMS structures". Proc. SPIE. Reliability, Packaging, Testing, and Characterization of MEMS/MOEMS IV. 5716: 182. Bibcode:2005SPIE.5716..182W. doi:10.1117/12.590013. S2CID 110785119.
- ^ Walecki WJ, Lai K, Souchkov V, Van P, Lau SH, Koo A (2005). "Novel noncontact thickness metrology for backend manufacturing of wide bandgap light emitting devices". Physica Status Solidi C. 2 (3): 984–989. Bibcode:2005PSSCR...2..984W. doi:10.1002/pssc.200460606.
- ^ Walecki W, Wei F, Van P, Lai K, Lee T, Lau SH, Koo A (2004). Tanner DM, Rajeshuni R (eds.). "Novel low coherence metrology for nondestructive characterization of high-aspect-ratio microfabricated and micromachined structures". Proc. SPIE. Reliability, Testing, and Characterization of MEMS/MOEMS III. 5343: 55. doi:10.1117/12.530749. S2CID 123249666.
- ^ High-resolution 3-D imaging of surface damage sites in fused silica with Optical Coherence Tomography. Lawrence Livermore National Laboratory. November 6, 2007. UCRL-PROC-236270. Archived from the original. You must specify the date the archive was made using the
|archivedate=parameter. https://e-reports-ext.llnl.gov/pdf/354371.pdf. Retrieved on December 14, 2010. - ^ (2004) "Interferometric Metrology for Thin and Ultra-Thin Compound Semiconductor Structures Mounted on Insulating Carriers" in CS Mantech Conference..
- ^ Walecki WJ, Pravdivtsev A, Santos II M, Koo A (August 2006). "High-speed high-accuracy fiber optic low-coherence interferometry for in situ grinding and etching process monitoring". Proc. SPIE. Interferometry XIII: Applications. 6293: 62930D. Bibcode:2006SPIE.6293E..0DW. doi:10.1117/12.675592. S2CID 121209439.
- ^ See, for example: "ZebraOptical Optoprofiler: Interferometric Probe".
- ^ {{{1}}} patent {{{2}}}; {{{1}}} patent {{{2}}}; {{{1}}} patent {{{2}}}.
- ^ Walecki WJ, Szondy F, Wang A (30 April 2009). Xiao H, Fan S (eds.). "Fiber optics low-coherence IR interferometry for defense sensors manufacturing" (PDF). Proc. SPIE. Photonic Microdevices/Microstructures for Sensing. 7322: 73220K. Bibcode:2009SPIE.7322E..0KW. doi:10.1117/12.818381. S2CID 120168355.
- ^ Dufour M, Lamouche G, Gauthier B, Padioleau C, Monchalin JP (13 December 2006). "Inspection of hard-to-reach industrial parts using small diameter probes" (PDF). SPIE Newsroom. doi:10.1117/2.1200610.0467. Retrieved December 15, 2010.
- ^ Dufour ML, Lamouche G, Detalle V, Gauthier B, Sammut P (April 2005). "Low-Coherence Interferometry, an Advanced Technique for Optical Metrology in Industry". Insight: Non-Destructive Testing and Condition Monitoring. 47 (4): 216–219. CiteSeerX 10.1.1.159.5249. doi:10.1784/insi.47.4.216.63149. ISSN 1354-2575.
- ^ Boppart, Stephen (11 June 2014). "Developing new optical imaging techniques for clinical use". SPIE Newsroom. doi:10.1117/2.3201406.03.
- ^ Al-Azri K, Melita LN, Strange AP, Festy F, Al-Jawad M, Cook R, et al. (March 2016). "Optical coherence tomography use in the diagnosis of enamel defects". Journal of Biomedical Optics. 21 (3): 36004. Bibcode:2016JBO....21c6004A. doi:10.1117/1.jbo.21.3.036004. PMID 26968386.
- ^ Iino Y, Ebihara A, Yoshioka T, Kawamura J, Watanabe S, Hanada T, et al. (November 2014). "Detection of a second mesiobuccal canal in maxillary molars by swept-source optical coherence tomography". Journal of Endodontics. 40 (11): 1865–8. doi:10.1016/j.joen.2014.07.012. PMID 25266471.
- ^ Subhash, Hrebesh M.; Hogan, Josh N.; Leahy, Martin J. (May 2015). "Multiple-reference optical coherence tomography for smartphone applications". SPIE Newsroom. doi:10.1117/2.1201503.005807.
- CS1 الفرنسية-language sources (fr)
- CS1 maint: unflagged free DOI
- CS1 errors: unsupported parameter
- Short description is different from Wikidata
- Articles containing إنگليزية-language text
- Pages using Lang-xx templates
- Articles with unsourced statements from June 2015
- Articles with unsourced statements from March 2019
- مقالات بالمعرفة بحاجة لذكر رقم الصفحة بالمصدر from October 2016
- All pages needing factual verification
- Wikipedia articles needing factual verification from October 2016
- Pages using div col with small parameter
- التصوير المقطعي للترابط البصري
- إجراءات العين
- طب الليزر
- معدات طبية
- تصوير بصري
- بصريات

![{\displaystyle I=k_{1}I_{S}+k_{2}I_{S}+2{\sqrt {\left(k_{1}I_{S}\right)\cdot \left(k_{2}I_{S}\right)}}\cdot Re\left[\gamma \left(\tau \right)\right]\qquad (1)}](https://wikimedia.org/api/rest_v1/media/math/render/svg/e90b482fe73988b986f3ebc89f0ff288bf6d67d9)



![{\displaystyle \gamma \left(\tau \right)=\exp \left[-\left({\frac {\pi \Delta \nu \tau }{2{\sqrt {\ln 2}}}}\right)^{2}\right]\cdot \exp \left(-j2\pi \nu _{0}\tau \right)\qquad \quad (2)}](https://wikimedia.org/api/rest_v1/media/math/render/svg/83da0d10e1049d9b461ab144e7b9dd7e58e85c45)











